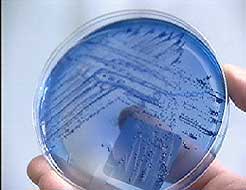

|
21/05/2004 16:53
Les deux enfants qui ont été retrouvés inconscients, mardi soir, dans l'arrondissement Sainte-Foy, ont bel et bien été intoxiqués au GHB, la drogue du viol. La police de Québec a confirmé les résultats de l'analyse toxicologique vendredi. Les enfants de deux ans et demi et cinq ans ont trouvé une fiole dans la maison familiale et ont ingurgité cette drogue à l'insu de leur mère, qui est d'ailleurs présentement interrogée par les policiers. Elle pourrait faire face à des accusations de négligence criminelle. La DPJ a confié la garde temporaire des enfants à leur grand-mère. Il semblerait que les jeunes victimes ne garderont aucune séquelle. Les enquêteurs devront déterminer d'où provient cette drogue.
En vidéo, écoutez les
explications de Jean-François Vézina, porte-parole de la police
de Québec. |
21/05/2004 16:43
Une femme de 34 ans a été accusée de conduite avec les facultés affaiblies causant la mort et des lésions corporelles, ainsi que d'homicide involontaire, au palais de justice d'Arthabaska. La récidiviste de l'alcool au volant, Louise Boissonneau, circulait à l'envers sur la route 116, à Wawick, lorsqu'elle est entrée en collision frontale avec la voiture des victimes. Aline Brossard-Grégoire, 54 ans, a perdu la vie, tandis que son mari a été blessé gravement. Le dépôt d'une accusation d'homicide involontaire est plutôt inhabituelle dans ce type de cause. Le ministère public souhaite ainsi faire un exemple de cette récidiviste qui a été reconnue coupable à trois reprises de conduite avec les facultés affaiblies. En vidéo, écoutez les explications de Jean-François Desbiens.
Copyright © 1998-2003 Groupe TVA
inc. - Tout droits réservés
|
21/05/2004 15:54
Un automobiliste dans la jeune vingtaine a comparu au palais de justice de Sorel-Tracy pour avoir blessé deux adolescentes, jeudi soir, à Pierreville, dans le Centre-du-Québec. Jean-Éloi Proulx a été accusé de conduite avec facultés affaiblies causant des lésions et de méfaits. Il a aussi été accusé d'entrave au travail des policiers, puisqu'il a résisté à son arrestation. Les deux adolescentes ont été happées par le véhicule de Proulx alors qu'elles marchaient en bordure de la route 226. Elles souffrent toutes deux de commotions cérébrales et de fractures aux membres inférieurs. En vidéo, écoutez les explications de Julie Grenon.
Copyright © 1998-2003 Groupe TVA
inc. - Tout droits réservés
|
|
21/05/2004 13:14
L'enquête pour remise en liberté sous caution du récidiviste de l'alcool au volant Carmond Lévesque, arrêté mercredi à Laval, est reportée à vendredi prochain. D'ici là, il restera incarcéré et devra subir une évaluation thérapeutique. Cette expertise pourrait permettre au tribunal de forcer l'homme de 65 ans à suivre un programme de désintoxication pour obtenir une remise en liberté. Carmond Lévesque a été arrêté 14 fois en état d'ébriété au volant. Il est accusé de conduite sous l'influence de l'alcool, de bris de probation et de refus de se soumettre à l'alcootest. Copyright © 1998-2003 Groupe TVA inc. - Tout droits réservés |
21/05/2004 08:05
Deux autres accidents impliquant l'alcool au volant sont survenus jeudi soir, dont un a été mortel. À Victoriaville, une femme de 54 ans a été tuée dans une collision entre deux voitures sur la route 116. Un prélèvement sanguin a été demandé sur la conductrice fautive. À Pierreville, en Montérégie, deux adolescentes ont été happées alors qu'elles marchaient en bordure de la route 226. Le conducteur de l'automobile a été arrêté pour conduite avec facultés affaiblies. Il devrait comparaître vendredi au palais de justice de Sorel-Tracy.
Copyright © 1998-2003 Groupe TVA
inc. - Tout droits réservés
|
|
20/05/2004 16:45
Un homme a été atteint d'un projectile d'arme à feu à sa sortie d'un dépanneur, en milieu d'après-midi, jeudi, à Montréal. L'homme dans la vingtaine a été grièvement blessé alors qu'il sortait d'un dépanneur de la rue Bourque, dans l'arrondissement de Dorval. Il a été transporté à l'hôpital et repose dans un état critique. Un suspect a été arrête, mais les policiers recherchent toujours deux hommes qui ont pris la fuite. L'un des suspects est âgé entre 25 et 30 ans. Il mesure environ 1,80 mètre et portait un pantalon beige avec un chandail à carrés bleu et blanc. L'incident est survenu devant une dizaine de témoins. En vidéo, écoutez les explications de Jean-François Guérin. Copyright © 1998-2003 Groupe TVA inc. - Tout droits réservés |
20/05/2004 11:00
Un jeune homme de 18 ans a perdu la vie dans une collision frontale survenue, mercredi soir, à La Présentation. La tragédie s'est produite sur le rang des Grands Étangs quand un des conducteurs a perdu la maîtrise de son véhicule dans une courbe. Il a alors été heurté de plein fouet une voiture qui arrivait en sens inverse. Le conducteur est décédé; les deux personnes qui se trouvaient dans l'autre voiture ont été blessées sérieusement.
Copyright © 1998-2003 Groupe TVA
inc. - Tout droits réservés
|
20/05/2004 10:46
À Saint-Eustache, deux motocyclistes ont perdu la vie, mercredi soir, lors d'une collision frontale avec une voiture. L'impact s'est produit boulevard Arthur-Sauvé, quand les deux motocyclistes ont quitté leur voie et ont été surpris par un véhicule qui venait en sens inverse. Les victimes sont deux hommes de 46 et 47 ans. Ceux-ci sont décédés sur le coup. Des motocyclistes qui accompagnaient les victimes affirment qu'une autre voiture leur aurait coupé la voie. Les victimes auraient tenté de l'éviter en se rendant dans la voie inverse.
Copyright © 1998-2003 Groupe TVA
inc. - Tout droits réservés
|
|
20/05/2004 10:07
À Valleyfield, le père de Benoît Dupras, ce garçon de 11 ans tué par un récidiviste de l'alcool au volant, entame une campagne contre les chauffards. Selon Mario Dupras, la mort de son fils doit dissuader les automobilistes de conduire en état d'ébriété. Il promet d'ailleurs de s'en charger personnellement en surveillant lui-même les environs des bars de Valleyfield. M. Dupras a acheté un véhicule et compte l'identifier comme une voiture de patrouille en y apposant l'inscription: «L'alcool au volant tue». Le père de Benoît se dit incapable de pardonner à Yvon Arsenault, responsable de la mort de son fils. «Le curé à l'église m'a demandé mon pardon... je ne suis pas capable...» En vidéo, Georges Pothier s'entretient avec Mario Dupras. Copyright © 1998-2003 Groupe TVA inc. - Tout droits réservés |
20/05/2004 09:13
À Montréal, les autorités ont retrouvé sain et sauf l'enfant de quatre ans qui avait été enlevé par l'ex-conjoint de sa mère. Les policiers ont mis la main au collet du kidnappeur, jeudi matin, après une poursuite qui a duré une dizaine de minutes dans le nord de Montréal. Le suspect a été blessé à une jambe lors de la poursuite. Il se trouvait au volant d'une minifourgonnette blanche en compagnie du jeune garçon. L'enlèvement s'était produit vers 22h, mercredi soir, dans l'arrondissement de Rivière-des-Prairies. Le garçon revenait de l'église à pied en compagnie de sa grand-mère au moment des faits. Plus tôt dans la journée, l'homme de 25 ans avait eu une altercation avec la mère du garçon. Il l'avait suivie à la sortie de son travail et l'avait frappée. Craignant des représailles, la dame avait alors confié son fils à sa grand-mère.
En vidéo, regardez le reportage de Jean-François Guérin.
Copyright © 1998-2003 Groupe TVA
inc. - Tout droits réservés
|
|
20/05/2004 07:54
À Montréal, un enfant de quatre ans a été kidnappé dans le quatrier Rivière-des-Prairies mercredi soir. Le suspect, l'ex-conjoint de la mère, a cueilli le garçon alors qu'il revenait de l'église en compagnie de sa grand-mère. L'enlèvement s'est produit au coin des rues Charles-Renaud et Louis-Lumière. Le suspect est reparti avec l'enfant à bord d'une minifourgonnette blanche de marque Chrysler. Il a été aperçu pour la dernière fois avec le bambin près de la station de métro Henri-Bourassa. Le kidnappeur est un individu de race noire, âgé de 25 ans. Il mesure 1,85 mètre, a les cheveux tressés et était vêtu d'une chemise grise et d'un pantalon beige au moment des faits. Le garçon, aussi de race noire, portait une chemise bleu à motifs et un short rouge. Plus tôt dans la journée, la mère du jeune garçon avait été victime de violence conjugale. Les policiers demandent à la population de communiquer au 911 pour toutes informations supplémentaires. Le suspect n'est pas le père de l'enfant, mais a vécu trois années avec lui. En vidéo, écoutez les explications de Pascale Déry. Copyright © 1998-2003 Groupe TVA inc. - Tout droits réservés |
|
19/05/2004 12:43
Carmond Lévesque, ce récidiviste de l'alcool au volant arrêté, dans la nuit de mardi à mercredi, à Laval, a comparu mercredi après-midi devant le tribunal. L'homme de 65 ans a été formellement accusé de conduite en état d'ébriété, bris de probation et refus de se soumettre à l'alcootest. Il restera détenu jusqu'à son enquête pour remise en liberté, vendredi. Il s'agit de sa 14e infraction pour alcool au volant. L'homme, qui conduisait de façon erratique, a été épinglé par des patrouilleurs, vers 3h. Son permis de conduire était pourtant suspendu. Il avait réussi à subtiliser les clefs de la voiture d'un membre de sa famille. Après avoir été emmené au poste de police, il a refusé de se soumettre à l'alcootest.
En vidéo, écoutez les
explications de Maxime Landry.
|
|
19/05/2004 20:28
Au Saguenay, un adolescent de 14 ans a reçu sa sentence mercredi, pour avoir incité sa nièce de cinq ans à des attouchements sexuels, en décembre dernier. Il avait déjà reconnu sa culpabilité et disait regretter son geste. Le juge l'a condamné à 75 heures de travaux communautaires. La sentence a provoqué la colère des parents de la victime, qui estiment que la peine est beaucoup trop légère, compte tenu du traumatisme qu'a subi leur fille. En vidéo, regardez le reportage de Jean Houle. Copyright © 1998-2003 Groupe TVA inc. - Tout droits réservés |
|
19/05/2004 19:01
À Québec, une fillette de deux ans et demi et son frère de cinq ans ont été gravement intoxiqués par une substance qui pourrait être du GHB, cette fameuse drogue du viol. Peu après leur retour de la garderie, les deux enfants sont tombés dans un état d'inconscience pendant plus de trois heures. Ils ont rapidement été conduits à l'hôpital. Les policiers croient qu'ils auraient ingurgité le contenu d'un flacon qui se trouvait dans la résidence familiale. Les symptômes des enfants et des produits retrouvés sur place laissent croire qu'il pourrait s'agir effectivement de GHB. Les enfants ont subi des prises de sang, mais ce n'est que jeudi qu'on aura les résultats de l'analyse toxicologique. Copyright © 1998-2003 Groupe TVA inc. - Tout droits réservés |
|
19/05/2004 12:57
Le récidiviste Yvon Guérin a finalement accepté de plaider coupable à une accusation d'ivresse au volant au palais de justice de Valleyfield. En décembre 2001, le chauffard a fauché mortellement Michel Laplante alors qu'il était en état d'ébriété. Son avocat avait d'abord réclamé un arrêt des procédures, mais il a changé de stratégie devant le refus du juge. L'accusé a a été arrêté de nouveau la fin de semaine dernière pour conduite avec facultés affaiblies. Il reviendra en cour le 3 juin pour sa remise en liberté. En vidéo, écoutez les explications d'André Jobin. Copyright © 1998-2003 Groupe TVA inc. - Tout droits réservés |
|
18/05/2004 16:45
Un homme de Montréal a été condamné à un an de prison pour avoir provoqué la fausse couche de sa conjointe. L'accusé a administré un médicament à la femme de 36 ans à son insu pendant une relation sexuelle. Une heure plus tard, la femme enceinte de trois mois souffrait de violentes contractions. Garry Bourgeois lui a tout avoué pendant le trajet à l'hôpital. L'homme d'affaires de 46 ans avait plaidé coupable. En vidéo, voyez le reportage d'André Jobin. Copyright © 1998-2003 Groupe TVA inc. - Tout droits réservés |
|
18/05/2004 16:12
La police de Laval a procédé à l'arrestation de quatre jeunes hommes qui seront notamment accusés de complot, de menaces de mort, de séquestration, d'agression armée et de prise d'otage. Les suspects, âgés entre 20 et 22 ans, ont été arrêtés dans une résidence de la rue Vanier lundi soir, alors qu'ils détenaient une adolescente de 17 ans. La jeune femme a indiqué aux policiers que son petit ami avait été enlevé par ses agresseurs, mais qu'elle ignorait ce qu'il lui était arrivé. L'homme de 18 ans se trouvait à la Cité de la santé, où il était traité pour des blessures au thorax causées par une arme blanche. Un des suspects était sous le coup d'un mandat d'arrestation pour une autre affaire de menaces de mort. C'est d'ailleurs ce qui a amené les policiers à se présenter à son domicile lundi soir. Copyright © 1998-2003 Groupe TVA inc. - Tout droits réservés |
|
18/05/2004 15:01
Le chauffard qui serait à l'origine du décès du jeune Benoît Dupras a renoncé mardi à sa remise en liberté au palais de justice de Valleyfield. Yvon Arsenault est accusé de conduite en état d'ébriété ayant causé la mort. La défense n'a pas fourni les motifs de cette décision peu fréquente dans ce genre d'affaires. Un accusé agit habituellement de la sorte lorsqu'il admet que sa détention est nécessaire pour des raisons sérieuses ou que sa libération pourrait choquer la collectivité. Yvon Arsenault a happé mortellement le jeune cycliste de 11 ans la semaine dernière. Il avait déjà été arrêté auparavant à deux reprises pour conduites avec les facultés affaiblies. En vidéo, écoutez le reportage de Pascale Déry. Copyright © 1998-2003 Groupe TVA inc. - Tout droits réservés |
À Saguenay, un homme ayant aidé sa conjointe à se suicider a écopé d'une peine d'emprisonnement de 12 mois. Évode Pelletier avait plaidé coupable aux accusations qui pesaient contre lui. En mars 2001, l'homme s'était procuré du cyanure qu'il avait remis à sa conjointe. Cette dernière était dépressive depuis plusieurs années et était à la recherche une substance qui lui permettrait de s'enlever la vie sans violence. Évode Pelletier a assisté au suicide de sa conjointe. Il n'a émis presque aucun regret. La fille de la défunte se dit satisfaite du jugement, mais elle ne peut s'empêcher de croire que sa mère pourrait être encore en vie sans l'intervention de l'accusé. Copyright © 1998-2003 Groupe TVA inc. - Tout droits réservés |
|
18/05/2004 10:34
À Montréal, un homme de 22 ans a été poignardé, lundi soir, dans le quartier Saint-Michel. L'agression s'est produite au coin du boulevard Robert et de la 25e Avenue. La victime a été agressée par quatre suspects de race noire, âgés de 18 et 19 ans. Elle a subi de graves blessures, mais on ne craint pas pour sa vie La victime connaissait ses agresseurs. La police est toujours à leur recherche. L'événement serait relié à un gang de rue. Copyright © 1998-2003 Groupe TVA inc. - Tout droits réservés |
|
17/05/2004 20:24
Les policiers ont procédé la fin de semaine dernière à l'arrestation d'un homme qui conduisait son véhicule sous l’effet de l’alcool, à Montréal. Yvon Guérin a été accusé le lendemain de conduite en état d'ébriété et de bris de conditions. Il s’agit en fait d’un récidiviste de l’alcool au volant qui n'a toujours pas été puni, même s'il a déjà causé la mort d'un homme. L’accident dans lequel il a été impliqué s’est produit en décembre 2001, mais le procès a avorté. Son avocat a d’ailleurs l’intention de demander au juge de retirer les accusations, sous prétexte qu’il n’a plus de juridiction. En vidéo, regardez le reportage de Félix Séguin. Copyright © 1998-2003 Groupe TVA inc. - Tout droits réservés |
|
16/05/2004 15:17
Un drame familial est survenu ce dimanche en début d'après-midi, à Saint-Eustache. Un homme de 48 ans aurait abattu sa femme de 44 ans avec une carabine, pour ensuite retourner l'arme contre lui. À l'arrivée des policiers, l'homme était déjà décédé. Sa femme a été transportée à l'hôpital de Sainte-Eustache, où on n'a pu que constater son décès. Un adolescent de 14 ans se trouvait à l'intérieur de la maison au moment du drame. Il a également été transporté à l'hôpital, où il est sous observation. Le couple a également deux autres enfants de 18 et 20 ans, qui étaient absents lors des événements.
En vidéo, écoutez les
explications de Marie-Christine Bergeron.
|
|
15/05/2004 19:17
En Estrie, des bénévoles ont commencé à arpenter les berges de la rivière Coaticook samedi pour tenter de retrouver le corps de Julie Bureau, disparue en septembre 2001. On veut ainsi vérifier les dires d'un voyant, qui affirme que le cadavre de la jeune fille s'y trouve. Pour le moment, les recherches ont été vaines. Léon Péron, un homme de 84 ans, a récemment annoncé aux parents de Julie Bureau que leur fille avait été agressée sexuellement, tuée et puis jetée dans la rivière Coaticook. Les policiers ne participeront pas aux recherches, qui seront surpervisées par l'équipe Recherche et Sauvetage de la MRC de Coaticook. La jeune fille de 14 ans a été vue pour la dernière fois le 26 septembre 2001 après être sortie du restaurant McDonald de Coaticook.
En vidéo, voyez le reportage
d'Isabelle Dorais.
|
14/05/2004 13:37
Au palais de justice de Montréal, le fonctionnaire Jean-François Guay a été reconnu coupable d'avoir retenu les services sexuels d'une adolescente moyennant rétribution, mais il a été acquitté de l'accusation d'agression qui pesait contre lui. Le jury composé de neuf hommes et trois femmes délibérait depuis trois jours. Contrairement aux autres procès tenus dans ce dossier, les jurés n’ont pas demandé à entendre à nouveau les témoignages de la jeune victime et de l’accusé. Jean-François Guay était accusé d’avoir agressé sexuellement une jeune prostituée de 15 ans. La justice a conclu que Jean-François Guay aurait dû savoir que la jeune fille avait 15 ans. Toutefois, le jury n'a pas cru que le fonctionnaire avait sodomisé la jeune fille, comme elle le prétendait. D'ailleurs, lorsque le juge Fraser Martin a transmis ses directives au jury, il avait mentionné aux membres d’être très prudents avec le témoignage de la jeune fille. Selon lui, elle manquait de crédibilité, puisqu’elle a admis avoir menti dans le passé. Rappelons d'ailleurs que la jeune fille avait témoigné au procès de Robert Gillet, mais que ce dernier a été acquitté des chefs la concernant. Interrogé à la sortie du palais de justice, Jean-François Guay était visiblement soulagé d'avoir été acquitté du chef d'agression sexuelle qui pesait contre lui. Il a affirmé qu'il souhaitait désormais tirer un trait sur le passé et recommencer à zéro. En vidéo, écoutez les explications de Sophie Bérubé.
Copyright © 1998-2003 Groupe TVA
inc. - Tout droits réservés
|
14/05/2004 09:26
Les policiers n'ont toujours pas retrouvé le corps d'Anne Lapointe, portée disparue depuis le 6 mai à Marieville, en Montérégie. Les enquêteurs décideront aujourd'hui s'il est pertinent de poursuivre les recherches. Anne Lapointe aurait été assassinée par son conjoint, Christian Leclaire, qui a été accusé de meurtre non-prémédité au Palais de justice de Saint-Hyacinthe. Des opérations de ratissage dans une large région comprise entre Marieville et la petite municipalité d'Abercorn, dans les Cantons-de-l'Est, n'ont toutefois pas encore permis de retrouver le cadavre. On croit que Christian Leclaire aurait placé le corps de la victime dans un grand coffre qu'il a abandonné sur un terrain, près d'une route de gravier.
Copyright © 1998-2003 Groupe TVA
inc. - Tout droits réservés
|
|
14/05/2004 08:18
Dans les Laurentides, la vitesse d'un automobiliste lui a coûté la vie, la nuit dernière, sur une route de Sainte-Sophie. Sa camionnette est entrée en collision avec un poids lourd, sur la route 158. Le conducteur du véhicule n'a eu aucune chance. Les secouristes ont d’ailleurs mis plus d’une heure à dégager la victime de la carcasse de sa camionnette. Les réservoirs à essence du semi-remorque ont été endommagés par l'impact, ce qui a occasionné une fuite importante de carburant. Copyright © 1998-2003 Groupe TVA inc. - Tout droits réservés |
|
13/05/2004 20:01
(PC) - C'est une véritable histoire d'horreur qui s'est terminée, jeudi, au palais de justice de Trois-Rivières, alors qu'un homme de 54 ans de Sainte-Marie-de-Blandford a été reconnu coupable d'avoir maltraité les deux enfants de sa conjointe, entre 1989 et 1991. Selon les faits énumérés par le juge Pierre L. Rousseau, l'accusé s'est livré à des sévices sur les jeunes victimes, une fille et un garçon qui avaient entre 8 et 11 ans au moment des faits. À l'époque, l'accusé et la mère des enfants passaient leurs nuits à consommer de la cocaïne au son des chansons d'Elvis Presley. La violence était constante, toujours pour des motifs futiles. Les deux victimes ont eu droit presque quotidiennement à des coups de poing au visage ainsi qu'à des coups de pieds. La fillette s'est aussi fait plonger un bras dans l'eau bouillante. Il n'était pas rare que l'accusé pointe un fusil sur la petite la nuit et qu'il la force à le regarder se «shooter» de la cocaïne. Le garçon, lui, était souvent confiné à la grange de la fermette. L'accusé ne lui pardonnait rien. Ainsi, alors qu'il n'effectuait pas le travail demandé au goût de l'accusé, l'enfant recevait des coups de marteau sur chacun les auriculaires. Lorsque les enfants ont fini par être envoyés en famille d'accueil, ils étaient totalement hystériques. Ils étaient sales et répugnants et leur maigreur sautait aux yeux. Il a fallu des années avant que les enfants réapprennent à vivre normalement. Le garçon, devenu adulte, a décidé de poursuivre la direction de la protection de la jeunesse pour ne pas avoir pris au sérieux les signalements que lui et sa soeur faisaient. Le juge Rousseau a retenu les témoignages des victimes (aujourd'hui adultes) même s'il y avait quelques imprécisions et contradictions. La mère a aussi dit confirmé la plupart des sévices mentionnés par les enfants. Elle est aussi accusée et sa cause sera entendue dans quelques semaines. Quant à l'accusé, le juge Rousseau a dit qu'il n'avait aucune crédibilité, aucun remords. Le juge a fixé les plaidoiries sur sentence au 18 juin. Copyright © 1998-2003 Groupe TVA inc. - Tout droits réservés |
|
13/05/2004 17:45
Un suspect a été arrêté relativement à l'attaque d'une sexagénaire dans la nuit de mardi à mercredi, à Terrebonne. Les enquêteurs ont procédé à l'arrestation d'André Larochelle, 24 ans, à son domicile de Terrebonne. Des objets volés et une partie de l'arme du crime ont été retrouvés sur place. L'individu connu des milieux policiers a comparu au palais de justice de Saint-Jérôme. Il a été accusé de tentative de meurtre, de voies de fait et d'introduction par effraction. Le suspect avait agréssé la dame de 61 ans à l'aide d' un bâton de hockey. Copyright © 1998-2003 Groupe TVA inc. - Tout droits réservés |
|
13/05/2004 13:18
À Trois-Rivières, Robert Moffat a été acquitté de l'accusation d'homicide involontaire qui pesait contre lui relativement au décès de Gilles Marin, battu à mort en juillet 1997. Impassible depuis le début de son procès, l'homme de 39 ans était visiblement soulagé de la décision des jurés. Il n'est toutefois pas au bout de ses peines. Moffat doit continuer d'attendre derrière les barreaux la tenue de son procès pour une série de vols dans des commerces, totalisant un demi-million de dollars. Dans plusieurs de ces dossiers, un autre individu, Michel Morin, doit aussi répondre des mêmes crimes que Moffat. Le procès doit commencer le 7 juin au palais de justice de Shawinigan. Une centaine de témoins seront entendus. En vidéo, regardez le reportage de Ghyslain Morrissette. Copyright © 1998-2003 Groupe TVA inc. - Tout droits réservés |

13/05/2004 08:24
À Marieville, les recherches policières pour retrouver le corps d'Anne Lapointe, qui aurait été tuée par son conjoint, n'ont toujours pas apporté de résultats. Des dizaines de kilomètres ont été fouillés sans qu’aucune trace de la victime ne soit retrouvé. Les recherches ont repris jeudi. Lundi, Christian Leclaire, 42 ans, a été accusé de meurtre non prémédité. Il se serait débarrassé du corps en le plaçant dans un coffre enveloppé d'une nappe, qu'il aurait par la suite abandonné en bordure d'une route entre Marieville et Abercorn, en Montérégie. Les policiers demandent toujours l'aide du public. Quiconque aurait aperçu la Pontiac Sunbird 1993 du suspect, de couleur bleue, immatriculée 288 JXP, est prié de se manifester.
Copyright © 1998-2003 Groupe TVA
inc. - Tout droits réservés
|
|
13/05/2004 07:48
Le chauffard ivre qui a heurté à mort un jeune cycliste, mercredi soir, dans le secteur Saint-Timothée à Valleyfield, a été accusé de conduite avec facultés affaiblies ayant causé la mort. Yvon Arseneault, 57 ans, citoyen de Valleyfield, a comparu devant le tribunal jeudi matin. Plusieurs proches de la jeune victime étaient présents. Benoit Dupras, 11 ans, a été happé par la camionnette du chauffard, vers 20 heures, dans une courbe de la rue Hébert, dans le secteur Saint-Timothée. La jeune victime a été projetée à une cinquantaine de mètres. Arsenault est un récidiviste de l'alcool au volant. En vidéo, voyez les reportages de Jean-François Guérin et Félix Séguin. Copyright © 1998-2003 Groupe TVA inc. - Tout droits réservés |
12/05/2004 17:05
À Marieville, la police a entrepris des recherches mercredi matin dans le but de retrouver le corps d'Anne Lapointe, qui aurait été tuée par son conjoint. Christian Leclaire, 42 ans, a été accusé lundi de meurtre non prémédité. Il se serait débarrassé du corps en le plaçant dans un coffre enveloppé d'une nappe verte. Le coffre aurait été abandonné en bordure d'une route entre Marieville et le village d'Abercorn, en Montérégie. Les policiers demandent l'aide du public. Le suspect roulait à bord d'une Pontiac Sunbird 1993, de couleur bleue, immatriculée 288 JXP. En vidéo, écoutez les explications de Félix Séguin.
Copyright © 1998-2003 Groupe TVA
inc. - Tout droits réservés
|
|
12/05/2004 16:25
À Baie-Comeau, la Commission scolaire de l'Estuaire a congédié une enseignante soupçonnée de violence physique et verbale envers ses élèves. Le comité exécutif a pris cette décision avant même de connaître le verdict de la cour. Le procureur de la couronne n'a pas encore entendu tous les parents qui ont porté plainte. L'enseignante, qui compte 26 ans d'expérience, est suspendue de ses fonctions depuis le 21 avril. Le syndicat a bien l'intention de porter cette décision en arbitrage, même si la commission scolaire affirme catégoriquement que la décision est sans appel. Copyright © 1998-2003 Groupe TVA inc. - Tout droits réservés |
|
12/05/2004 13:05
Au palais de justice de Joliette, Magloire Poissant a plaidé coupable à quatre accusations de meurtre non prémédité et une accusation de tentative de meurtre. Il a automatiquement été condamné à la prison à perpétuité. Le 29 décembre 2001, à Lavaltrie, Magloire Poissant a tué son ex-conjointe, Collette Harnois, et deux de ses fils, des adolescents. Un ami des garçons, qui se trouvait en visite à la maison, a aussi été assassiné. Le troisième fils de Colette Harnois a échappé au carnage, mais il a été blessé à la tête. Magloire Poissant n'acceptait pas la séparation de son couple. Tant la Couronne que la défense ont suggéré que Magloire Poissant ne soit pas admissible à une libération conditionnelle avant 15 ans. Or, la juge a plutôt statué qu'il n'y aurait pas droit avant 25 ans.
En vidéo, écoutez les
explications d'André Jobin.
|
12/05/2004 08:58
Au Lac Saint-Jean, un homme de 65 ans est décédé mardi à l'Hôtel-Dieu de Roberval après avoir contracté le streptocoque bétahémolytique du groupe A, mieux connu sous le nom de «bactérie mangeuse de chair». La bactérie, qui peut se manifester sous diverses formes, a été fatale pour le sexagénaire en l'affligeant d'une sévère pneumonie. L'homme est mort à peine 48 heures après son admission à l'hôpital, dimanche. La bactérie mangeuse a fait une autre victime à Québec le 2 avril dernier. C'est une femme de 55 ans qui est décédée. La bactérie s'était attaquée à la gorge de la patiente, ce qui a empêché toute amputation. En vidéo, Véronyque Tremblay fait le point sur la situation avec le Dr John Carsley, responsable de l'unité des maladies infections à la Direction de la santé publique de Montréal.
Copyright © 1998-2003 Groupe TVA
inc. - Tout droits réservés
|
12/05/2004 07:39
Une trentaine de personnes ont été arrêtées mercredi à la suite d'une opération policière menée contre un des derniers repaires des Hells Angels au Québec. Environ 250 policiers des différents corps policiers de la Mauricie, ainsi que de l'escouade régionale mixte, ont investi le local de Trois-Rivières mercredi matin. Une vingtaine d'autres sites ont aussi été visés par des mandats de perquisition. Les personnes arrêtées devaient comparaître au palais de justice de Trois-Rivières mercredi après-midi pour répondre à des accusations de gangstérisme, de trafic de stupéfiants et de complot pour trafic de drogue. L'enquête visait notamment deux membres en règle des Hells Angels, François Hinse, qui a été arrêté, et son frère Marc-André, qui est toujours recherché. Cette opération découle d'une enquête de 20 mois sur un réseau de trafic de stupéfiants lié aux Hells Angels. En vidéo, écoutez les explications de Marie-Christine Bergeron.
Copyright © 1998-2003 Groupe TVA
inc. - Tout droits réservés
|
|
11/05/2004 19:03
La police de Montréal lance un appel au public pour faire progresser son enquête à la suite du meurtre d'une femme de l'arrondissement Saint-Laurent, le 25 avril dernier. Monique Gravel, 49 ans, avait été retrouvée morte dans sa chambre à coucher par sa fille de 15 ans. L'adolescente et son frère de 13 ans rentraient, ce dimanche soir-là, d'un week-end chez leur père. Les policiers ne connaissent pas le mobile du meurtre mais ils n'écartent aucune piste. Le logement de Monique Gravel ne présentait aucune marque d'introduction par effraction. Les policiers demandent de communiquer avec eux à toute personne ayant aperçu, le dimanche 25 avril, des individus au comportement louche dans l'arrondissement Saint-Laurent. Le ou les suspects ont pris la fuite avec le véhicule de la victime, une Oldsmobile Aurora de couleur or.
En vidéo, écoutez les
explications de Jean-François Guérin.
|
11/05/2004 17:51
La police est toujours à la recherche du corps d'Anne Lapointe, cette femme de Marieville qui aurait été tuée par son conjoint. Christian Leclaire, 42 ans, a été accusé mardi de meurtre non prémédité. Il se serait débarrassé du corps en le plaçant dans un coffre enveloppé d'une nappe verte. La malle aurait été abandonnée en bordure d'une route entre Marieville et le village d'Abercorn, en Montérégie. Les policiers demandent l'aide du public pour mettre en place tous les morceaux du casse-tête. Le suspect roulait à bord d'une Pontiac Sunbird 1993, de couleur bleue, immatriculée 288 JXP. En vidéo, écoutez l'entrevue de la soeur de la victime, Linda Lapointe, avec Pierre Bruneau.
Copyright © 1998-2003 Groupe TVA
inc. - Tout droits réservés
|
|
10/05/2004 21:15
Un homme de 42 ans a comparu, lundi, au palais de justice de Saint-Hyacinthe, pour le meurtre non prémédité de sa conjointe. Anne Lapointe avait été portée disparue par sa famille, le 6 mai dernier. Son corps n'a pas été retrouvé, mais l'accusé, Christian Leclaire, s'en serait débarrassé en le plaçant dans une malle recouverte de nappes vertes. Les policiers demandent l'aide du public pour localiser la malle. Elle aurait été abandonnée en bordure d'une route entre Marieville et le village d'Abercorn, en Montérégie.
En vidéo, voyez le reportage
de Karine Champagne.
|
|
10/05/2004 19:47
L'alcool au volant est un fléau qui ne s'endigue pas facilement. Un homme de Québec vient d'être arrêté pour la 11e fois parce qu'il conduisait en état d'ébriété. Son cas n'est pas isolé; une personne sur quatre, arrêtée pour ivresse au volant, récidive au cours des cinq années suivantes. La Société de l'assurance automobile se demande comment venir à bout de ces irréductibles contrevenants. Ainsi, au palais de justice de Québec, deux récidivistes cumulent ensemble 20 accusations de conduite avec facultés affaiblies. Le premier, Robert Saint-Hilaire, 51 ans, en est à sa 11e offense. Sa feuille de route commence en 1975 et se termine vendredi dernier, moment ou les policiers de la Sûreté du Québec l'ont intercepté lors d'une opération de contrôle. Son sang contenait 1,81 milligrammes d'alcool. L'autre individu, Guy Soussy, en serait, lui, à sa 9e offense. Arrêté samedi, il devra expliquer au juge la présence de 1,06 milligramme d'alcool dans son sang. Ils font partie des 4000 récidivistes de l'alcool au volant au Québec, sur qui la répression n'a aucun effet. Les lois sont pourtant de plus en plus sévères: saisie des véhicules, perte du permis de conduire, plan d'encadrement de neuf mois, éthylomètre, campagnes publicitaires. Ces moyens de répression parviennent à convaincre 75% des conducteurs pris en défaut, mais ils laissent les 25% restants plutôt froids.
En vidéo, voyez le reportage
de Carl Langelier.
|
|
10/05/2004 13:24
Léo Fournier, 75 ans, a été comdamné à un an de prison ferme, lundi matin, au palais de justice de Longueuil. Le militaire à la retraite a été reconnu coupable d'agressions sexuelles sur les deux filles de sa conjointe. Les faits remontent aux années 70, alors que les plaignantes étaient âgées de 7 à 13 ans. La mère s'est rangée du côté de son conjoint lorsque les deux femmes ont décidé de porter plainte. Le juge Denis Bouchard a refusé de donner une sentence avec sursis au septuagénaire qui n'éprouve aucun remords pour les gestes qu'il a posés. En vidéo, écoutez les explications d'André Jobin. Copyright © 1998-2003 Groupe TVA inc. - Tout droits réservés |
|
10/05/2004 09:33
Une voiture a explosé lundi matin, rue Masson, à Longueuil. L'explosion s'est produite lorsqu'un homme, qui n'a pas encore été identifié, a tourné la clef pour faire démarrer le véhicule. La victime a été transportée rapidement au Centre hospitalier Charles-LeMoyne. Elle a été blessée gravement aux jambes et souffre d'un arrêt cardio-respiratoire. La police de Longueuil a confirmé qu'il s'agissait d'un attentat. Elle a ajouté que l'individu s'était déjà plaint d'avoir fait l'objet de menaces. Personne d'autre n'a été blessé lors de l'explosion, mais l'événement a créé une forte congestion dans le secteur. En vidéo, écoutez les explications de Pascale Déry. Copyright © 1998-2003 Groupe TVA inc. - Tout droits réservés |
|
09/05/2004 20:23
Un accident survenu dimanche matin dans la région de Bouctouche, au Nouveau-Brunswick, a fait quatre morts. Les trois hommes et la femme, tous âgés dans la vingtaine, se trouvaient dans le même véhicule qui a fait une violente embardée sur la route 515. Selon les premières constatations, la vitesse excessive semble être à l'origine de la tragédie. L'identité des victimes n'a pas été divulguée, mais on sait qu'elles sont toutes de la région de Kent. Copyright © 1998-2003 Groupe TVA inc. - Tout droits réservés |
|
09/05/2004 17:45
Un homme de 34 ans a perdu la vie dimanche lorsque son automobile a plongé dans les eaux de la rivière Saguenay, dans le secteur de Chicoutimi. En apercevant des pièces de la voiture sur le rivage, un passant a alerté les policiers. Les recherches ont permis de retrouver la victime, Daniel Fortier, qui se trouvait toujours à bord du véhicule. Les policiers ont remarqué de longues traces de freinage sur la chaussée. L'homme serait parti de chez lui samedi soir avec la voiture de sa mère, sans la permission de celle-ci. Il n'a pas été revu par la suite. La vitesse pourrait être en cause dans cette affaire. En vidéo, voyez le reportage de Sonia Lavoie. Copyright © 1998-2003 Groupe TVA inc. - Tout droits réservés |










 L'enfant
(petite photo) se porte bien et ne semble pas avoir subi de
mauvais traitements. Le suspect n'est pas le père de
l'enfant, mais il a vécu avec lui pendant trois années.
L'enfant
(petite photo) se porte bien et ne semble pas avoir subi de
mauvais traitements. Le suspect n'est pas le père de
l'enfant, mais il a vécu avec lui pendant trois années.